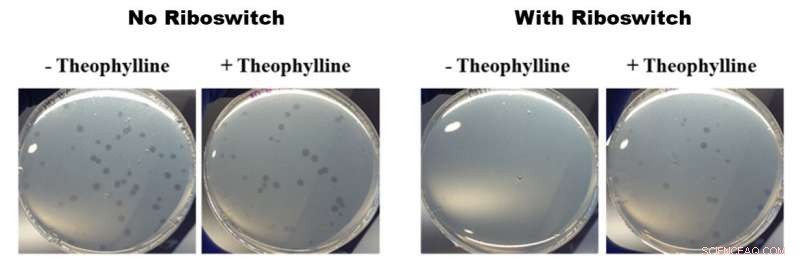
Predatory Bacteria: Pioneering a New Class of Antibiotics

B. bacteriovorus predation cycle. B. bacteriovorus has two life phases: 1) searching for prey, and 2) entering the prey and feeding. During this second phase, the bacteria consume their prey from the inside, allowing them to grow and elongate before separating into 3 to 6 new B. bacteriovorus cells. These cells then escape the now-dead prey and begin a new life cycle. Credit: American Chemical Society
In 2016, the World Health Organization named antibiotic resistance as "one of the biggest threats to global health, food security, and development today." The announcement cited a growing list of infections, such as tuberculosis and gonorrhea, that are becoming more difficult to treat each year as resistance to current antibiotic treatments increases. Yet antibiotics are essential—without them, the human race would be plagued by persistent infections. So what is the solution to ensuring continual treatment while also addressing the alarming rise in resistance?
One potential solution lies within a unique type of predatory bacteria that feeds on other bacteria, such as those that cause diseases. Dubbed "living antibiotics," this group of carnivorous fauna have caught researchers' attention, including those at the Okinawa Institute of Science and Technology Graduate University (OIST). In a recently published paper in ACS Synthetic Biology, OIST researchers have taken the first steps toward genetic manipulation of one such tiny cannibal, B. bacteriovorus. They have identified tools that may allow for the manipulation of genes that influence this bacteria's predatory behavior.
"In the future, we want to control the predation of the bacteria—the timing and extent of predation," explains Dr. Mohammed Dwidar from the Nucleic Acid Chemistry and Engineering Unit and first author on the paper. "[At the moment] we lack the basic engineering tools in order to do this."
B. bacteriovorus is harmless to humans yet lethal to its prey—Gram-negative bacteria—which includes baddies such as E. coli, Salmonella, Legionella, and others. As such, being able to control it could potentially treat many different types of infections. However, due to its unusual predatory nature and other unique features, genetic manipulation of B. bacteriovorus has been limited.
Effects of theophylline-activated riboswitches on growth of B. bacteriovorus. All of the photos in the figure above show petri dishes containing B. bacteriovorus and its prey E. coli. The two photos on the left show the growth of B. bacteriovorus in dishes not containing (-) and containing (+) theophylline without a riboswitch inserted in the genome. The right two photos show the growth of B. bacteriovorus modified with a riboswitch in dishes not containing (-) and containing (+) theophylline. The left photos show no difference in growth and the right photos show faster growth in presence of theophylline, meaning that the theophylline-activated riboswitches had an effect on the predatory behavior of B. bacteriovorus. Credit: American Chemical Society
The OIST researchers used riboswitches, which are gene expression-controlling tools known to function well in other bacteria, to tackle the challenge of understanding and manipulating B. bacteriovorus's predation. The way in which a gene is expressed follows a specific pathway—DNA is converted into RNA via transcription, RNA is converted into proteins via translation, and then the proteins carry out different functions. The riboswitch comes in at the translation phase. By putting a riboswitch at the beginning of a strand of RNA, and then "activating" it with a chemical, the riboswitch can start or stop the RNA from being translated into a protein.
For their study, the OIST researchers inserted a riboswitch into one of the genes believed to be important to B. bacteriovorus's predatory behavior: flagellar sigma factor fliA. They then activated it with the chemical theophylline. After placing the modified bacteria in petri dishes together with some delicious E. coli prey, the modified B. bacteriovorus seemed to multiply more quickly in presence of theophylline than in its absence. This quicker multiplication implies that B. bacteriovorus was consuming its prey faster, and thus multiplying faster. This in turn shows that the predatory lifecycle can be controlled by theophylline.
In addition to the "living antibiotic" end-goal, there are many more potential uses for easily manipulatable B. bacteriovorus cells. "People want organic food without chemicals," Dr. Dwidar explains. "The predatory bacteria may be a potentially safe alternative to antibacterial agents for some plant diseases. We can also use it for industry, for example, in water treatment plants."
"In the future, you could spray these bacteria on fresh food to protect against food poisoning," Professor Yohei Yokobayashi, who was also involved in the research, adds.
With the OIST researchers' results in hand, the next step is to learn more about B. bacteriovorus and the tools that might be able to control its behavior in order to one day realize its full antibiotic potential.